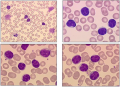
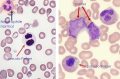

Catégorie:Oncologie
De médecine.top
Pages dans la catégorie « Oncologie »
Cette catégorie comprend 16 pages, dont les 16 ci-dessous.
Média dans la catégorie « Oncologie »
Cette catégorie comprend 18 fichiers, dont les 18 ci-dessous.
- Ann Arbor classification des lymphomes MKSAP.svg 605 × 384 ; 274 Kio
- Binet LLC.png 1 698 × 1 178 ; 337 Kio
- Breslow-scale-according-to-TNM-system W640.jpg 640 × 242 ; 22 Kio
- Caractéristiques lymphomes.png 1 964 × 1 452 ; 343 Kio
- FDA Approved CAR T-Cell Therapies Table.jpg 970 × 500 ; 97 Kio
- Gène de fusion bcr-abl, chromosome de Philadelphie.jpg 740 × 480 ; 48 Kio
- Leucémie lymphoblastique chronique.png 1 408 × 1 018 ; 2,15 Mio
- LLA vs LMA.png 1 912 × 720 ; 162 Kio
- Lymphomes non-hodgkiniens à cellules B.png 2 208 × 1 258 ; 324 Kio
- MRA18574-BreslowDepthFig-V2-Hex.png 400 × 386 ; 47 Kio
- Néoplasies myéloprolifératives OMS.png 1 684 × 1 052 ; 1,05 Mio
- Phases LMC.jpg 1 374 × 694 ; 80 Kio
- Polycythemia vera.png 1 352 × 1 012 ; 286 Kio
- Promyélocytes atypiques avec agots d'Auer.png 606 × 692 ; 485 Kio
- RAI modifié LLC.png 1 294 × 1 246 ; 255 Kio
- Signes de dysgranulopoïèse et blastose.png 1 388 × 908 ; 1,68 Mio
- Syndromes myélodysplasiques.jpg 1 016 × 605 ; 281 Kio
- Tumeurs pancréatiques.jpg 1 679 × 1 112 ; 286 Kio